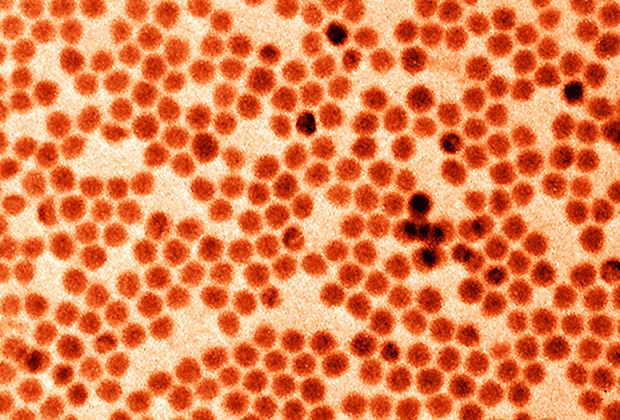

Zürcher Forscher haben Nanokristalle aus dem Halbmetall Antimon konstruiert, die wiederaufladbare Batterien mit hoher Ladekapazität ermöglichen könnten. Von der Marktreife sei die Antimon-Batterie jedoch noch Jahre entfernt, geben die Forscher zu bedenken.
Lithiumionen-Akkus liefern heutzutage zuverlässig Strom für elektronische Geräte. Doch für Elektroautos und Energiespeicher werden in Zukunft mehr und leistungsfähigere Batterien benötigt, wie die ETH am Dienstag mitteilte. Ausserdem könnte die hohe Nachfrage nach Lithium zu Engpässen führen.
In spezielle Form bringen
Antimon hat eine doppelt so hohe Ladekapazität wie das derzeit für Lithiumionen-Batterien verwendete Anodenmaterial Graphit. Dazu kommt, dass Antimon neben Lithium- auch Natrium-Ionen speichern könnte - eine günstige, da auf der Erde häufige Alternative zu Lithium.
Damit Antimon seine hohe Speicherfähigkeit erlangt, muss es in eine spezielle Form gebracht werden. Dies ist nun den Forschern von der ETH Zürich und der Materialforschungsanstalt Empa unter Leitung von ETH-Professor Maksym Kovalenko mit den Nanokristallen gelungen. Sie berichten darüber im Fachblatt «Nano Letters».
Herstellung noch zu teuer
Noch sei die Herstellung der Nanokristalle in ausreichender Menge und Qualität zu teuer, obwohl das Verfahren an sich relativ einfach sei, erklärte Kovalenko in der Mitteilung.
Das Team will nun zusammen mit seinem Industriepartner eine günstigere Synthesemethode finden. Bis eine Natriumionen-Batterie mit Antimonelektrode auf den Markt kommen könnte, dürfte es wohl mindestens zehn Jahre dauern, schätzt Kovalenko.